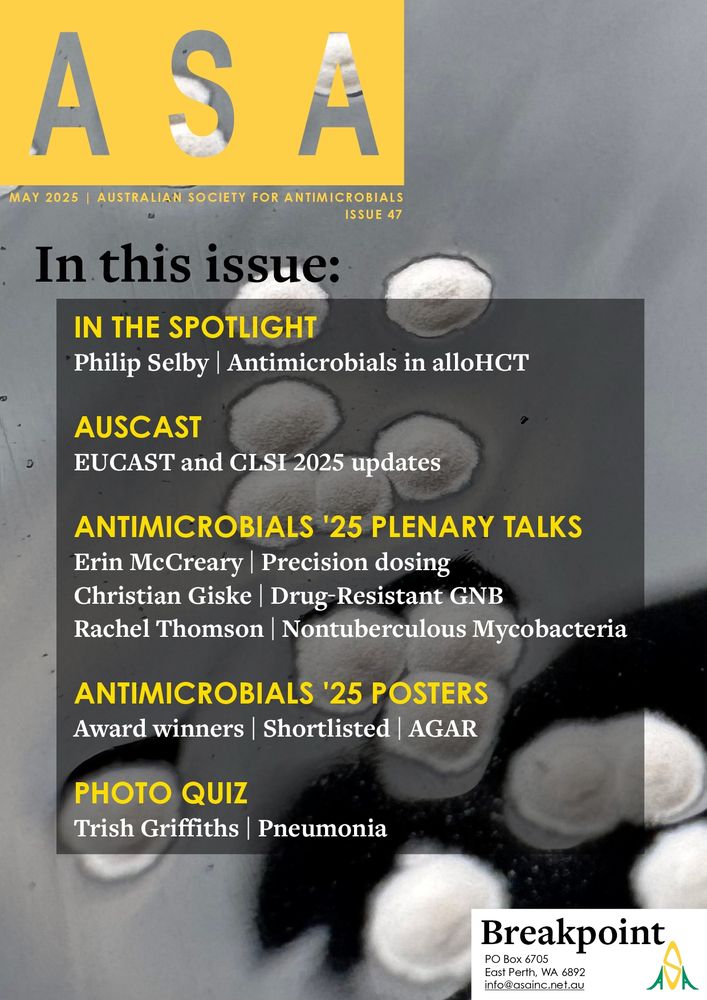

Australian Society for Antimicrobials
@ausantibiotics.bsky.social
430 followers
200 following
55 posts
Supporting education, stewardship, management, policies and research in relation to Antibiotics. Annual Meetings.
http://www.asainc.net.au
Posts
Media
Videos
Starter Packs
Reposted by Australian Society for Antimicrobials
Reposted by Australian Society for Antimicrobials
Reposted by Australian Society for Antimicrobials
Reposted by Australian Society for Antimicrobials
Phil Selby
@philgrastim.bsky.social
· Feb 22
Reposted by Australian Society for Antimicrobials